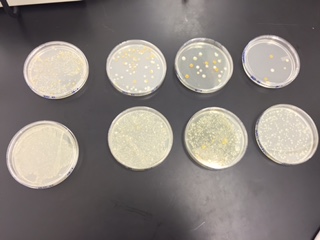
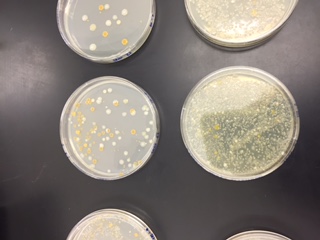
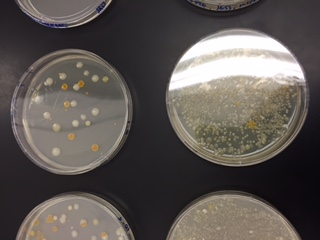

User:Jess Kowall/Notebook/Biology 210 at AU
March 22, 2015-JK
Embryology and Zebrafish Development
Purpose: The purpose of this experiment was to observe and characterize the stages of embryonic development using zebrafish, and to set up an experiment that tested the effects of environmental factors on zebrafish development. In this case, the effects of nicotine on zebrafish were observed. It was predicted that nicotine would inhibit and hurt the growth and development of the zebrafish.
Materials and Methods: The materials in this lab included zebrafish embryos, of which one group was placed in a water control and one was placed into a treated solution (in this case, nicotine). Twenty clear embryos were placed into each of the petri dishes, and the dishes were filled with either the control or the test solution. The plates were observed three times a week for two weeks, and changes regarding hatching, life status, size and development, and movement. Dead fish were removed at each check, and fresh water or solution was put into the dishes. The zebrafish were fed with paramecium.
Data:
Table 1-Zebrafish Data Collection for Treatment Group
Treatment Date Hatched Alive Stage Movement Eye size (micrometers) Yolk size (micrometers) Notes 2/18/2015 0 20 18 hrs N/A 2/20/2015 2/23/2015 10 14 72 hrs Shaking, doesn't move unless agitated 30 75 petruding mouth, full fin development 2/25/2015 0 10 (new) 60 hrs Fast, freely swims on it's own without agitation. Doesn't react to agitation 2.75 5.75 Started over, 10 new 2/27/2015 4 freely swims 3/2/2015 ALL DEAD; DIDNT START OVER
Table 2-Zebrafish Data Collection for Control Group
Control Date Hatched Alive Stage Movement Eye size (micrometers) Yolk size (micrometers) Notes 2/18/2015 0 20 18 hrs N/A 2/20/2015 2/23/2015 5 6 48 hrs fast, freely moves, reacts to agitation 30 70 2/25/2015 1 6 72 hrs normal movement, responds to agitation 30 35 petruding mouth, full sized fins 2/27/2015 5 normal movment on most 30 30 3/2/2015 0 3 full grown shaking and spaztic 30 25
Conclusion:
The purpose of this experiment was to design a procedure that allowed for the observation of environmental effects on the development of embryonic zebrafish. The treated group of zebrafish were put into a nicotine solution, and it was observed that these fish did not grow at a normal rate, and had a higher mortality rate than the control group of fish. By the end of the observation period, the treated fish were all dead, and there were no living measurements to be made. As predicted, the harsh environmental effects of nicotine were detrimental to the growth and survival of the zebrafish embryo.
March 4, 2015-JK
PCR Analysis of Bacteria
Purpose: The purpose of this experiment was to use a PCR reaction and then a database of nucleotide sequences to identify bacteria present in the hay infusion cultures from each individual transect of land, and to determine if the PCR reaction showed the bacteria to match with our original identification the bacteria.
Materials and Methods: We used a sequence of DNA taken from bacteria grown on agar nutrient plates, which originated as a sample from our transect. We performed a PCR reaction to replicate the DNA, so that it could be analyzed for more accurate identification.
Results:
Species: Chryseobacterium sp. WR12 16S ribosomal RNA gene, partial sequence
>MB24-For_16S_H03.ab1 NNNNNNNNNNNNNCNACNNTGCAGCCGAGCGGTANANATTCTTCCGAATCNTNNGAGCGNNNTACGGGTGCGGAACACGT GTGCAACCTGCCTTTATCTCGGGGATANCCTTTCCAAAGGAATATTAATACCCCATAACATANTGCNGGGGAAACTTGGG ATGAANACTACTTGTGGAAANGGATGGGCACGCGCCAGATTAGATAGTTGGTGGGGTAACGGCTCACCAAGTCTACGATC TTTANGGGGCCTGAGAGGGTGATCCCCCACACTGGTACTGAGACACGGACCAGACTCCTACGGGAGGCAGCAGTGAGGAA TATTGGACAATGGGTGAAACCCTGATCCAGCCATCCCGCGTGAGCGACGACGGCCCTATGGGTTGTAAACTTCTTTTGTA TGAGGAAAAACCTANGTACTTGTACCCCGCTGAANGTACTATACNAGTAAACACCGGCTAACTCCGTGCCATCACCCNCG GTACTACAGAGGGTGCGGNCGTTATCCGGATTTAATGNNTTNAAAGNGTCCNTAGGCNGANCTGTNCNTCNNNGNTGAAA TCTCATCNCTTANCTGTGANNCTGCCNTTGATACTGCANGTCTTGANTGTTGTTGAAGTANCTGGAATAANTTNTGTANC GNTGANNTGCATNNATATNACTTANAACACAANTTGCNAAGGCAGGTTACTATCCTGCNACTGACNCTNATGGACGAAAN CNTGCGNAGCGAACANGATTAAATACNNNGNNAGTCCACNCCCTACACAATGCANACTCNTTTNNNGATTNTCCGATTCN GACACTANNCCAAAGTGATAACTTANNCNCCTGNGGANTACGTNCNCANNAATGAAACTCANANGAATTGACANNNGACC CGCACNNNCGCTGGNATTANGTNGGNTNNANTTCTATNANNNTNNANGAACCTTACCATNGCCTTANNTGNNANATGACN GGNNTANNAATNAAANTTTTCNTCNGANCATTTTTTNNAANNTGCTNCATGGNTGNTCGTCNGNNNNNNNNNNNNCNNNN NNNAGGNNNATTTNNNGN
Conclusion:
The bacteria was identified as a gram-negative bacteria of the chryseobacterium genus. This is a correction over our previous identification of the bacteria, which we initially had labeled as a gram-positive species. The mislabeling of the initial bacteria sample was most likely due to error in the staining process.
February 18, 2015 -JK
A Study of Invertebrates on Farmland Introduction- Lab 5 built on previous transect observation and identification by focusing on the invertebrates inhabiting the individual transects. Invertebrates are a class of organisms that do not have a backbone, and include mostly arthropods, which consist of arachnoids and insects. A major goal of this lab observation was to recognize the complexity of the invertebrate group. Other objectives for the lab activities included understanding the important functions of invertebrates and learning how simpler systems evolve and become complex systems. Materials and Methods- The materials used in this lab included matter collected previously from the transect and utilized in a Berlese funnel to trap invertebrates, microscopes for observation, live Planaria, nematodes, and coelomate for observation of movement, and a dichotomous key for the identification of different invertebrates trapped in the Berlese funnel. Five different types of invertebrates were observed, characterized, and identified from the transect samples. Data and Observations- The three types of worms (Planaria, nematodes, and coelomate) that were observed all had slightly different types of movement, which can be attributed to the structure of their bodies. The Planaria had a rhythmic, flowing movement, the nematodes’ muscles contracted much less rhythmically and more jerkily, and the coelomate’s muscles contracted in equal rhythm.
Organism (Phylum and Class) Length in mm Number in Sample Description of Organism
arthropoda, arachnida, araneae (spider) 160 2 8 legs, hairy body
arthropoda, insecta, hymenopta 100 1 ant; dark body with a narrow connection, two antennae
arthorpoda, insecta, isoptera 75 1 termite; broad connection between thorax and body, dark, thick rounded body
arthorpoda, insecta, collembola (springtail) 105 1 longer, light colored body, forked tail
arthropoda, arachnida, araneae (spider) 80 2 8 legs, two clear body shapes
According to the data collected regarding the invertebrates inhabiting the transect, it appears that spiders were the most frequent organism encountered. The isoptera was the smallest invertebrate encountered, and the spiders were the largest. The sizes of the invertebrates ranged from 75-160mm.
chordate, animal
Possible vertebrate species that could potentially inhabit farmland include: chickens-chordate, animal deer-chordate, animal mice-chordate, phylum crows/corvus-chordate, animal sparrows-chordate, animal
The five previously listed vertebrates all benefit from the biotic and abiotic characteristics of farmland. Chickens, deer, sparrows, and mice feast on the vegetation frequently present on farmland, and crows eat small animals such as mice and other living organisms that inhabit farmland. Farmland also provides shelter in the way of trees, brush, and soft soil for these animals. These vertebrates contribute to the community constructed on this type of land by helping to control vegetation growth, controlling insect populations, and turning up soil present on farmland.
This lab was successful because a significant number of vertebrates were identified through collection from the transect. The observation and characterization yielded information about many kinds of organisms, which showed the vast habitation of small organisms on a piece of farmland. The data collected from this lab wrapped up a thorough examination of a small piece of land in terms of the different protists, bacteria, plants, invertebrates, and possible vertebrates living on the land.
References-
Bentley, Meg. 2015. A Laboratory Manual to Accompany: General Biology II. American University: Washington, DC. Pg.45-49
February 11, 2015-JK Plantae and Fungi
Lab 4 revolved around the collection of different plant species for observation and identification in the lab. The lab also included a set-up component for a future experiment involving the observation and identification of invertebrates. The main goals of this lab included understanding the various characteristics and wide diversity of plants. A second major goal was to appreciate fungi in terms of the importance of their function.
The materials for this lab included five plant species collected from the individual transect, cross sections made from those plants, microscopes for the observation of the plants and fungi species, and collected "leaf litter" too make funnels in order to trap invertebrates. The lab also called for charts of monocot and ditto characteristics in order to further describe the plant identifications.
Five plant species were collected from the transect. The first plant was identified as kale, a member of the brassica genus. Kale has clustered green leaves with netlike veins, qualifying it as a dicot plant. It has flowers for reproduction, and is vascular. The cells of the kale leaves measured to be five micrometers. The second plant gathered was from a corn plant, a member of the zea genus. Corn plants are monocot, and therefore have long green leaves that have parallel veins. They also have flowers for reproduction and are vascular. The corn plant cells measured as four micrometers. The third plant collected was english thyme, a plant of the thyme genus that has clusters of medium sized, round green leaves, with netty veins. The plant is a vascular dicot, grows close to the ground, and uses flowers for reproduction. The cell sizes measured as six micrometers. The fourth plant gathered was identified as brussel sprouts, a member of the brassica genus. The brussel sprouts had sprouts on the stem instead of leaves, grew upward, were vascular, and used flowers for reproduction. The cell size was measured at two micrometers. The last plant gathered remains unidentified both in species and genus, but was characterized by its tiny green leaves, ground covering nature, vascularity, and flowers as mechanisms of reproduction. The cell sizes measured 12 micrometers. No seeds were collected in the samples. Fungi were also observed under the microscope in this lab. Fungi sporangia were seen, otherwise known as the place in fungi where spores form. This location is important because it is the site of meiosis, and is responsible for the reproduction of the fungi. Three species of fungi were observed under the microscope: mushrooms, a member of the basidiomycota lineage, rhizopus nigrican, a member of the zygomycota lineage, and focus, a member of the basidomycota lineage.
This lab was successful because there was effective gathering, observation, and identification of different plant species from the transect. Fungi forms were observed under the microscope and divided into their lineages. The funnels were set up to trap invertebrates for future examination.
February 4, 2015-JK
Microbiology and Identifying Bacteria
Lab 3 was a multi-faceted procedure designed to meet several diverse goal. The purposes of this experiment included attempting to understand the different characteristics of bacteria, observing antibiotic resistance and the growth of antibiotic resistant bacteria, and learning how to use DNA sequences to identify species.This lab also included a final observation of our original hay infusion. In the lab, the prokaryotes making up the Domain Bacteria were studied in an attempt to achieve the stated lab goals.
The materials used in this lab included the original hay infusion culture, the serial dilution plates with bacteria growing on them made in the lab last week, slides and gram staining materials to stay the bacteria from the agar plates, a microscope to examine the stained bacteria, and tubes, a heat block, a centrifuge, and the PCR machine for the PCR reactions. In this lab, the hay infusion cultures were examined for a final time. The agar plates from the serial dilution were examined and characterized, some of the plates yielded bacteria samples that were stained using Gram's staining procedures for further characterization, and two samples of bacteria from the plates were selected to undergo a PCR reaction for examination next week in the lab.
Regarding the serial dilution plates, I do not predict much growth of the Domain Archaea, because they tend to grow in very extreme environments that we have not recreated in the lab. Regarding the final hay infusion culture observation, the culture has the same musty, lake water smell as last week, albeit the smell is definitely stronger, and has a thicker film of green and brown over the top than last week. A week is plenty of time for the species living in the culture to reproduce, so there is a high probability of even more organisms living in the culture than at observation last week. The differences in the observation of the hay culture can most likely be attributed to a different measure of life in the culture than last week's observation. Moving onto the serial dilution observations highlighted that the plates treated with tetracycline had universally less growth than their counterparts without tetracycline, indicating that there was definitely some effect to the growth of bacteria contributed by the antibiotic. However, some of the treated plates still grew bacteria in large numbers, especially the 10^-3 plate. The observations of the plates indicate that the antibiotics definitely affect the growth of the bacteria as there is less growth on the treated plates than on the untreated plates, but observations also show significant growth in spite of the antibiotic, indicating that there are antibiotic-resistant bacteria present on the plates. All four treated plates showed growth, so there were resistant bacteria on each of the four plates from the serial dilution. Tetracyclines are very general antibiotics that protect against a wide range of bacteria by stopping protein synthesis of the bacteria, but have been limited in recent usage due to growing bacterial resistance. Tetracyclines have been found to be useful against many gram-positve and gram-negative bacteria, as well as many atypical organism such as protozoan parasites (Chopra 2001). For the Gram staining procedures, the plates with and without tetracycline labeled 10^-3 and 10^-5 were stained and observed. The plate labeled 10^-5/no tetracycline was purple, cylindrical, motile, and gram positive. The plate labeled 10^-3/no tetracycline was purple, circular, nonmotile, clumped closely together, and gram positive. The plate labeled 10^-3/with tetracycline was purple, small, circular, nonmotile, clumped together, and gram positive. The plate labeled 10^-5/with tetracycline was purple, clumped together in distinct straight lines, and gram positive.
The procedures in this lab were successful because the objectives of the experiments were achieved, and there was successful setup fro next lab with the PCR reactions. The nutrient and tetracycline agar plates with bacteria were characterized, and examples of antibiotic resistance were seen among the present bacteria. The bacteria from the plates was stained and were identified as gram positive or gram negative based on the results. The PCR reactions were successfully set up fro further examination next week in the lab.
Chopra I, Roberts M. Tetracycline Antibiotics: Mode of Action, Applications, Molecular Biology, and Epidemiology of Bacterial Resistance. Microbiology and Molecular Biology Reviews 2001;65(2):232-260. doi:10.1128/MMBR.65.2.232-260.2001.
January 28, 201-JK Identifying Algae and Protists of the Transect
Lab 2 featured hay infusions made of soil samples from transects, made in lab last week. The purpose of this experiment was to utilize the hay infusion in order to identify different algae and protists living in each individual transect of land. This objective had secondary goals of learning how to use a dichotomous key to identify unknown protists and algae, understanding different traits and characteristics of the different algae and protists in the transect, and to carefully examine algae and protists from the transect. The dichotomous key is a step by step direction in identifying each of the organisms under the microscope, by examining characteristic and matching them to a guide. Using the dichotomous key, the organisms were sorted into the algae, which are the photosynthesizing organisms, and the protist, which is the nutrient-consuming organism. A serial dilution was also made from the transect's hey infusion cultures for examination in a later lab.
The materials used in this experiment included the hay infusion culture from the transect, a dichotomous key for identification, wet mounts made from the top and bottom of the hay infusion, and agar treated petri dishes and sterile broth tubes for the serial dilution. After practicing using the dichotomous key on known organisms, wet mounts of the hay infusion culture were made, with care to represent different niches of the ecosystem. These were examined under the microscope, and the protists and algae present were identified with the dichotomous key. Following this identification portion of the lab, the serial dilution was made. This was done with four sterile broth tubes, in which the first contained 100 microliters of the culture, and then 100 microliters of that mixture was added to the next tube, and then so on, so that each of the four tubes contained and exponentially diluted amount of the original hay infusion culture. This same process was done on agar treated petrol dishes.
The hay infusion culture from the American University Community Garden had mold and algae growing over the top layer of the ecosystem, and had a strong smell reminiscent of dirty lake water. There were small white dots spotting the surface of the culture as well. The rest of the culture was a mixture of different dark green colors, depending on what niche of the ecosystem was being examined. When taking samples from different niches, it was seen that some samples were taken from close proximity of plant matter, and some were not. Because protists are nutrient-consuming organisms instead of making their own food, it is reasonable to believe that many of the samples near plant matter will contain protists, and that algae will be found further away from other plants, as they are photosynthesizing organisms. There were five samples pulled from the hay infusion culture: three from the bottom area of the culture, and two from the top area of the culture. There was plant matter in the vicinity of the samples pulled from the top. When using the dichotomous key to identify present algae and protists, it was found that paramecium bursaria, spirostomum, blepharisma, pandorina, paranema, and paramecium multimicronucleatum. The paramecium bursaria measured approximately 80 micrometers, is motile, and is classified as a protozoan. The spirostomum measured approximately 2 micrometers, is motile, and belongs to the protist category. The blepharisma measured approximately 100 micrometers, and is a motile protist. The pandorina measured approximately 140 micrometers, and is a motile organism belonging to the algae category. The paranema measured approximately ten micrometers, and is a motile protist. Lastly, the paramecium multimicronucleatum measured approximately 160 micrometers, and is a motile protist. The only photosynthesizing organism identified was the pandorina, the only algae found in the culture. If the hay culture was left to grow for another two months, the algae population would probably remain relatively the same, because the protists use their nutrients for food, but the competition for protist would grow, especially since the plant matter originally present in the soil samples will die out because of a lack of reproduction. The pandorina satisfies the five conditions for life because it is composed of cells, participates in an energy exchange when it uses photosynthesis, utilizes information exchange with its surroundings in order to be able to undergo photosynthesis, is able to reproduce by asexual and sexual reproduction, and it can be assumed that the pandorina is continually evolving.
The ecosystem created by the hay infusion culture yielded important information about the various algae and protists that can live in such a small environment. Samples yielded six different kinds of organisms, and further study of the samples surely would have shown that more organisms called the culture their home. Examination of the cultures at a later date may also have shown greater variation in organism inhabitants. The serial dilutions made in this lab will provide more information on the ecosystem, and further study will fill in kore of the details of the culture, and the transect, as a whole.
January 26, 2014-JK Transect Introduction: American University Community Garden
In lab 1, a transect of land was assigned to each group for observation. This lab was performed in an effort to practice characterizing the layout of a niche of land, with regards to its location, topography, and the organisms inhabiting it. The twenty by twenty meter transect of land assigned to each group was an example of biological diversity on American University's campus, and was also demonstrative of how complex a small niche of land can be. The transects featured both abiotic components, or nonliving things, and biotic organisms, or living things. The lab was an important step in understanding the components of an ecosystem, or a community of biotic and abiotic organisms.
Each group of students was assigned a twenty meter by twenty meter transect of land on campus, and was instructed to chart the topography, location, and inhabitants of the area of land. A soil sample was taken of the transect for further study in the lab.
Transect 4 was located in the American University Community Garden, a square of land that features four planting areas. The majority of the topography consisted of soil which was partially frozen from the cold temperatures, and the area of land surrounding the planters was a mixture of mulch/straw and soil. Two of the four planters had vegetation growing inside them, one with smaller plants and the other with tall plants, and the other two planters were simply filled with soil. A drawing of the transect is attached. The abiotic components of the transect included the soil and straw/mulch mixture and the planters. The biotic organisms included the two kinds of plants in the planters, and the bugs in the soil and on the plants. It can be assumed that there were also protists too small for the human eye to see living among the plants and soil.
The given transect was an example of a community because it featured a collection of species, and can be called an ecosystem because it is a larger representation of a community. The transect had identifiable abiotic and biotic components, which were listed in the discussion and can be seen in the transect diagram. The transect was an important piece of information in observing the qualities and characteristics of a niche of land, and yielded a significant amount of information for a relatively small piece of land. The transect also yielded a sample of soil for further study in the lab.
This is Jess!
test AP.